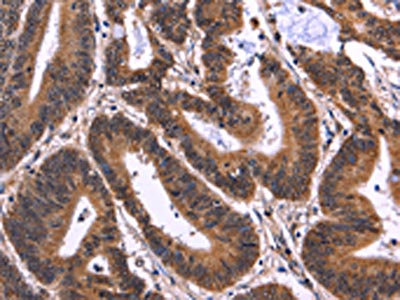

MSH4 Antibody
-
中文名稱:MSH4兔多克隆抗體
-
貨號:CSB-PA987494
-
規格:¥1100
-
圖片:
-
The image on the left is immunohistochemistry of paraffin-embedded Human colon cancer tissue using CSB-PA987494(MSH4 Antibody) at dilution 1/50, on the right is treated with fusion protein. (Original magnification: ×200)
-
The image on the left is immunohistochemistry of paraffin-embedded Human cervical cancer tissue using CSB-PA987494(MSH4 Antibody) at dilution 1/50, on the right is treated with fusion protein. (Original magnification: ×200)
-
-
其他:
產品詳情
-
產品描述:
The fusion protein of human MSH4 is used to immunized rabbits to generate the anti-MSH4 antibody. The resulting product is a polyclonal antibody and exists as an unconjugated IgG. It has undergone antigen affinity purification. And it can react with human and mouse samples. This MSH4 antibody has passed through the quality control via ELISA and IHC analyses. Its target protein MSH4 is a meiosis-specific homologue of the bacterial MutS mismatch repair protein that plays no role in mismatch correction and that is required for wild-type level of meiotic crossovers in budding yeast and nematode.
-
Uniprot No.:
-
基因名:MSH4
-
別名:hMSH4 antibody; MSH 4 antibody; MSH4 antibody; MSH4_HUMAN antibody; MutS homolog 4 (E. Coli) antibody; MutS homolog 4 antibody; MutS protein homolog 4 antibody
-
宿主:Rabbit
-
反應種屬:Human,Mouse
-
免疫原:Fusion protein of Human MSH4
-
免疫原種屬:Homo sapiens (Human)
-
標記方式:Non-conjugated
-
抗體亞型:IgG
-
純化方式:Antigen affinity purification
-
濃度:It differs from different batches. Please contact us to confirm it.
-
保存緩沖液:-20°C, pH7.4 PBS, 0.05% NaN3, 40% Glycerol
-
產品提供形式:Liquid
-
應用范圍:ELISA,IHC
-
推薦稀釋比:
Application Recommended Dilution ELISA 1:2000-1:10000 IHC 1:100-1:300 -
Protocols:
-
儲存條件:Upon receipt, store at -20°C or -80°C. Avoid repeated freeze.
-
貨期:Basically, we can dispatch the products out in 1-3 working days after receiving your orders. Delivery time maybe differs from different purchasing way or location, please kindly consult your local distributors for specific delivery time.
-
用途:For Research Use Only. Not for use in diagnostic or therapeutic procedures.
相關產品
靶點詳情
-
功能:Involved in meiotic recombination. Required for reciprocal recombination and proper segregation of homologous chromosomes at meiosis.
-
基因功能參考文獻:
- Study describes the first MSH4 mutation associated with POI and increases the number of meiotic/DNA repair genes formally implicated as being responsible for this condition. PMID: 28541421
- inactivation of MSH4 in germ cells may have played a role in the acquisition of additional TP53 and LATS1 germline mutations in a Li-Fraumeni family PMID: 25041856
- hMSH4 interacts with HDAC3. PMID: 24145748
- Our current study has revealed a role for hMSH4 in the maintenance of genomic stability by suppressing NHEJ-mediated DSB repair. PMID: 23725059
- mutation analysis of SYCP3, DNMT3L and MSH4 in patients with maturation arrest of spermatogenesis and couples with recurrent miscarriages PMID: 21126912
- The different properties associated with these two hMSH5 variants underscore the potential functional diversity of the human hMSH5 gene. PMID: 15907804
- the GPS2 might function in concert with hMSH4-hMSH5 during the process of homologous recombination. PMID: 16122992
- A review of the properties and functional roles of MSH4. PMID: 17127347
- Dimerization of MSH4 and MSH5 facilitates their nuclear localization suggesting that dimerization may regulate the intracellular trafficking of these proteins. PMID: 17869244
- Data have identified the interaction region between the individual subunits of hMSH4-hMSH5 that are likely involved in clamp formation and show that each subunit of the heterodimer binds ATP. PMID: 17977839
- Data show that there is no association between MSH4 gene mutation and premature ovarian failure. PMID: 18166824
顯示更多
收起更多
-
亞細胞定位:Chromosome.
-
蛋白家族:DNA mismatch repair MutS family
-
組織特異性:Testis and ovary specific.
-
數據庫鏈接:
Most popular with customers
-
-
YWHAB Recombinant Monoclonal Antibody
Applications: ELISA, WB, IHC, IF, FC
Species Reactivity: Human, Mouse, Rat
-
Phospho-YAP1 (S127) Recombinant Monoclonal Antibody
Applications: ELISA, WB, IHC
Species Reactivity: Human
-
-
-
-
-